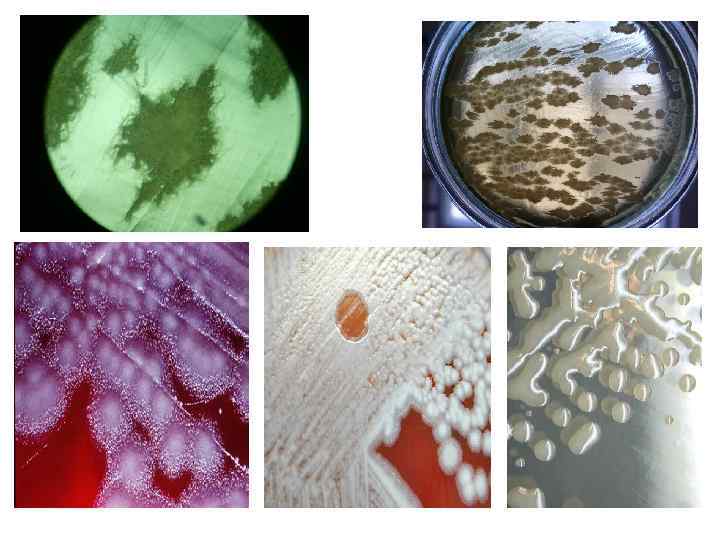
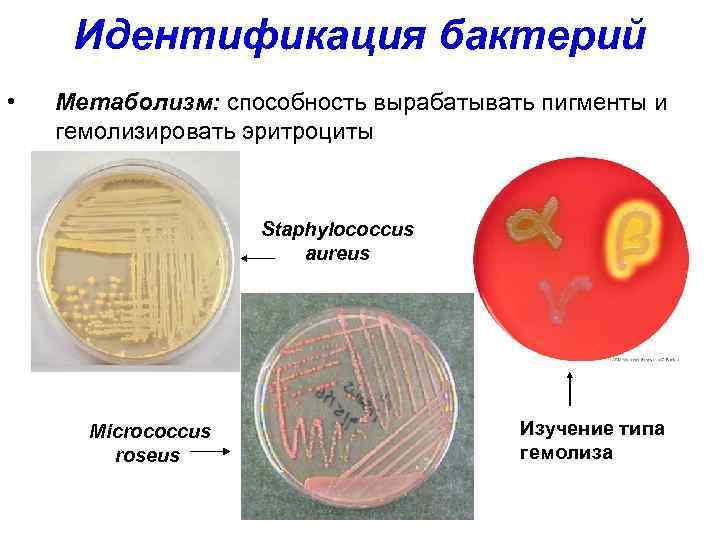
Идентификация бактерий • Метаболизм: способность вырабатывать пигменты и гемолизировать эритроциты Staphylococcus aureus Micrococcus roseus

ФИЗИОЛОГИЯ БАКТЕРИЙ.ppt
- Количество слайдов: 21

ТЕМА ЛЕКЦИИ:

Химический состав бактериальной клетки 100% ВОДА СУХОЙ ОСТАТОК 10 – 20% 80 – 90% Органические вещества 97% Белки Углеводы Липиды 52% 17% 9% Нуклеиновые кислоты 19% РНК 16% ДНК 3% Минеральные вещества 3% Азот, сера, фосфор, калий, кальций, магний, железо, марганец. Микроэлементы: цинк, медь, кобальт, барий

Метаболи зм (от греч. μεταβολή, «превращение, изменение» ) • набор химических реакций, которые возникают в живом организме для поддержания жизни. Эти процессы позволяют организмам расти и размножаться, сохранять свои структуры и отвечать на воздействия окружающей среды.

Существует две стадии метаболизма: 1. Катаболизм (дыхание) - сложные органические вещества деградируют до более простых (энергия накапливается в виде АТФ). 2. Анаболизм (питание) процесс с затратами энергии синтезируются такие вещества, как белки, сахара, липиды и нуклеиновые кислоты.

Классификация бактерий по типам питания и способам получения энергии

Типы переноса питательных веществ в бактериальную клетку: 1. Пассивный перенос: • простая диффузия – проникновение веществ в клетку в направлении градиента концентрации; • облегченная диффузия – протекает с участием белка-переносчика, но по градиенту концентрации. 2. Активный перенос: • с участием Na+–K+ насоса; • транспорт с учетом ионных градиентов; • транспорт путем векторного переноса групп.

Дыхание бактерий (энергетический метаболизм) Облигатные аэробы – реакции окисления осуществляются у них при участии молекулярного кислорода (микобактерии туберкулеза и др. ) Облигатные аэробы делятся на: v строгие аэробы – растут при нормальном парциальном давлении кислорода в тканях и питательных средах (холерный вибрион); v микроаэрофилы – растут при пониженном парциальном давлении кислорода (Helicobacter pylori). Облигатные анаэробы – способны существовать только в отсутствии свободного кислорода; дыхание происходит путем ферментации субстрата с образованием небольшого количества энергии (клостридии столбняка, ботулизма и др. ) Факультативные анаэробы – могут размножаться как при наличии молекулярного кислорода, так и при его отсутствии (энтеробактерии и др. )

Микроаэрофильные организмы • Требуют для своего роста присутствия кислорода в атмосфере или питательной среде, но в пониженных концентрациях по сравнению с содержанием кислорода в обычном воздухе или в нормальных тканях организма хозяина. • Проявляют чувствительность к антибактериальным препаратам, действие которых имитирует действие атомарного кислорода (повышение образования свободных радикалов) – нитроимидазолам: метронидазол, тинидазол.

СХЕМА ДЫХАНИЯ МИКРОБОВ RH 2 МАКРОЭРГИЧЕСКИЕ СВЯЗИ АТФ ПИРИДИНОВАЯ ДЕГИДРАЗА-2 Н (ДЕГИДРАЗЫ АКТИВИРУЮТ И ОТЩЕПЛЯЮТ Н 2, ВКЛЮЧАЯ ЕГО В ДАЛЬНЕЙШИЙ ОКИСЛИТЕЛЬНЫЙ ПРОЦЕСС) ПРОМЕЖУТОЧНЫЕ ПЕРЕНОСЧИКИ-2 Н (ЩАВЕЛЕВОУКСУСНАЯ, ЯБЛОЧНАЯ, ПИРОВИНОГРАДНАЯ, МОЛОЧНАЯ КИСЛОТЫ ФЛАВИНОВАЯ ДЕГИДРАЗА-2 Н ПРОМЕЖУТОЧНЫЕ ПЕРЕНОСЧИКИ-2 Н (ФУМАРОВАЯ КИСЛОТА, ГЛЮТАТИОН, ЦИСТИН, АСКОРБИНОВАЯ КИСЛОТА) ЦИТОХРОМЫ а, в, с ЦИТОХРОМОКСИДАЗА (ГЕМИННЫЙ ФЕРМЕНТ, АКТИВИРУЕТ КИСЛОРОД О 2) Н 2 О ПОЛНОЕ СЖИГАНИЕ ВОДОРОДА

ПИТАТЕЛЬНЫЕ СРЕДЫ • Простые • • мясо-пептонный бульон (МПБ) — жидкая среда мясо-пептонный агар (МПА) — плотная среда • Специальные - характеризуются добавлением специфического компонента или заменой основы. • • казеиново-угольный агар сывороточный агар кровяной бульон яичная среда Левенштейна-Йенсена • Элективные - характеризуются получением роста только интересующего микроорганизма. • • • желточно-солевой агар (ЖСА) — для стафилококка пептонная вода (1 %, p. H=8) — для холерного вибриона среда Мюллера — для сальмонелл селенитовая среда — для сальмонелл среда Леффлера — эффективна для коринебактерий дифтерии • Дифференциально-диагностические - позволяют произвести идентификацию отдельных типов, • • среды Гисса ( «пёстрый ряд» ) среда Сабуро — с добавлением антибиотика видов и групп бактерий.

КОЛОНИЯ • это видимое изолированное скопление представителей одного вида микроорганизмов, образующееся при размножении одной колониеобразующей единицы (КОЕ) на плотной питательной среде (на поверхности или в глубине её).

КОЛОНИИ • по величине — крупные (диаметр более 4— 5 мм), средние (2— 4 мм) и малые (1— 2 мм) • по форме — круглые, розеткообразные, листовидные и т. д. • по цвету, зависящему от пигмента — белого, ярко-синего, красного цветов и т. д. • по консистенции — сухие, влажные, сочные, слизистые • по поверхности — гладкие, морщинистые, исчерченные, плоские, выпуклые, плосковыпуклые, вдавленные • по краю — с ровными, волнистыми, бахромчатыми краями • по структуре — могут иметь аморфную, зернистую, волокнистую внутреннюю структуру • в чистой культуре, выращенной на скошенном питательном агаре, характер роста может быть сухим, влажным, ползучим, складчатым, пигментированным.

ИДЕНТИФИКАЦИЯ БАКТЕРИЙ Характер роста на плотной питательной среде: Форма колонии Поверхность Характеристика края колонии

Морфология колоний

Идентификация бактерий • Метаболизм: способность вырабатывать пигменты и гемолизировать эритроциты Staphylococcus aureus Micrococcus roseus Изучение типа гемолиза

ПРИЗНАКИ РОСТА НА ЖИДКОЙ ПИТАТЕЛЬНОЙ СРЕДЫ • В жидкой питательной среде одни бактериальные культуры дают: • диффузное помутнение, • Образуют придонный, пристеночный ростом. • Некоторые культуры образуют плёнки на поверхности среды, другие — осадок на дне пробирки.


СХЕМА РЕПРОДУКЦИИ ВИРУСА ГРИППА Нейраминидаза Гемагглютинин

СХЕМА РЕПРОДУКЦИИ ПИКОРНАВИРУСОВ
ФИЗИОЛОГИЯ БАКТЕРИЙ.ppt